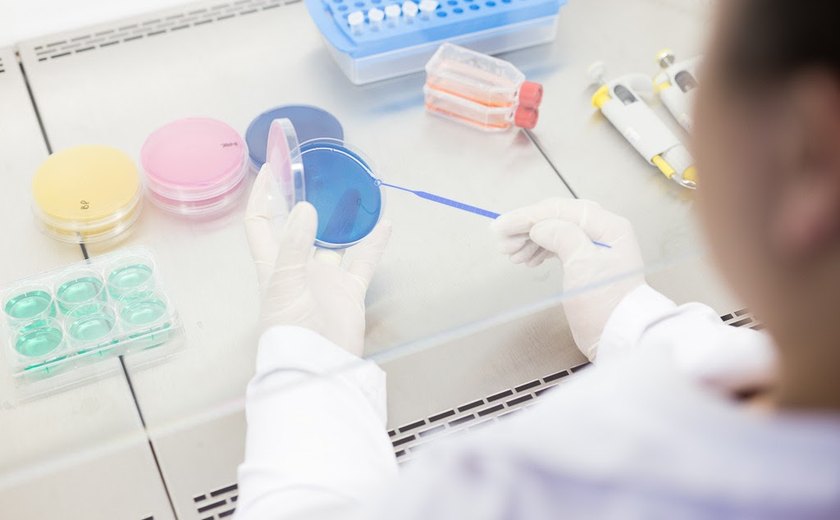
Professora de Biomedicina orienta sobre consumo de bebidas em embalagens

Geral
Professora de Biomedicina orienta sobre consumo de bebidas em embalagens
Em meio à folia, cuidados básicos evitam riscos de contaminação gastrointestinal; Biomedicina traz esclarecimentos.
O Carnaval é sinônimo de folia e diversão, mas é importante não deixar de lado a atenção à segurança alimentar, especialmente ao consumir bebidas em embalagens, alerta a Professora de Biomedicina do Centro Universitário São Camilo, Jeane Facioli. Em entrevista, ela esclarece os riscos e fornece dicas para aproveitar a festa sem descuidar da saúde.
"Apesar dos riscos de contaminação ao beber diretamente na garrafa ou lata, com cuidados básicos de higienização nada vai atrapalhar a folia", assegura a professora.
Segundo o Ministério da Saúde, as doenças gastrointestinais, comumente associadas ao consumo de alimentos e bebidas contaminados, podem ser causadas por diversos agentes, como Salmonella, Escherichia coli e Staphylococcus. A Professora Jeane Facioli destaca que nem sempre a presença desses microorganismos resulta em doença, sendo influenciada pela resposta imunológica individual e pela carga bacteriana do produto.
A manipulação inadequada dos isopores utilizados pelos vendedores ambulantes é apontada como um ponto crítico. "O gelo deve atender aos padrões de qualidade da legislação sanitária, assim como o isopor utilizado para armazenar as bebidas deve estar devidamente higienizado", destaca a professora.
A preocupação estende-se à manipulação das bebidas por mãos não higienizadas. A Professora Jeane ressalta a importância de lavar as mãos antes de tocar nos alimentos e bebidas, após ir ao banheiro e após manusear objetos sujos, destacando que a falta de higiene pode comprometer a qualidade do gelo e das bebidas.
O consumo direto na embalagem, seja garrafa ou lata, é desaconselhado devido ao risco de proliferação de microorganismos. "Caso o vendedor toque no local onde o consumidor põe a boca ao ingerir a bebida, o risco de contaminação é potencializado", alerta Jeane. A presença de guardanapos e copos disponíveis para os consumidores minimiza esse risco.
A professora sugere a utilização de lenços desinfetantes para higienizar embalagens, ou, alternativamente, o uso de canudos de papel. "São cuidados simples que, se tomados, vão deixar o Carnaval mais alegre e saudável", conclui Jeane Facioli.
 WhatsApp
WhatsApp
Receba notícias do Em Tempo Notícias no seu WhatsApp e fique por dentro de tudo! Basta acessar a nossa comunidade:
https://chat.whatsapp.com/K8GQKWpW3KDKK8i88MtzsuComentários
Os comentários são de inteira responsabilidade dos autores, não representando em qualquer instância a opinião do Em tempo Notícias ou de seus colaboradores.
últimas
-
INVESTIGAÇÃO
Gaspar mira em filho de Lula em CPMI e quer aprofundar investigação
-
Economia
Petrobras renova contratos de quase R$ 100 bi com a Braskem
-
Combate à criminalidade
Polícia apreende mais de 50 quilos de drogas após ação em Arapiraca
-
ORDENAMENTO
Projeto “Poste Limpo” avança em Maceió e remove fiação obsoleta de grandes avenidas
-
Área próxima à Praça Dois Leões
Rua Barão de Jaraguá recebe serviços da Operação Tampa Bueiro neste sábado











